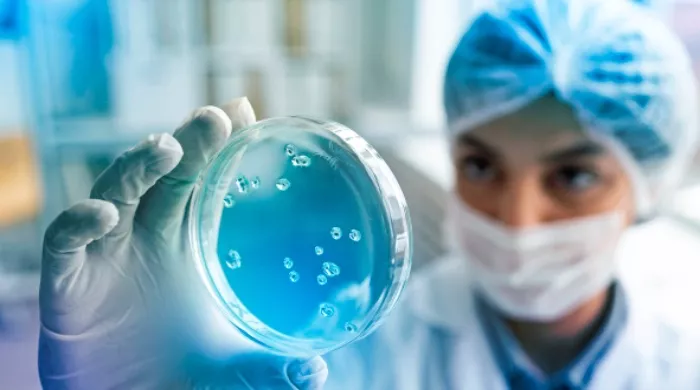
najsmešniji virus

NAJSMEŠNIJI VIRUS
Istina, jedan naš poznati lekar, doktor nauka, tvrdio je da je kovid najsmešniji virus ikada. Valjda je po toj izjavi i postao poznat.
Njemu i Bog gleda kroz prste.
Narodna
Lep je sunčani dan, koji mami napolje, iako je još uvek hladnjikavo, pogotovo za nekog koga pritiska osamdeset, i ovakvih i onakvih, godina života. Uostalom, za kraj zime sasvim prihvatljivo vreme.
Posle kraćag nakanjivanja, ipak odlučim da izađem u baštu, da počnem sa orezivanjem voća, jer ako budem oklevao krenuće pupoljci, a to dobri voćari ne rade. Stignem tako do najbliže voćke, a bila je to razgranata kajsija koju sam jako voleo, jer je, kad je mraz ne „obere“ u cvetu, obilno rađala vrlo kvalitetne plodove, koji su bili za svestranu upotrebu.
Osim što smo je u slast jeli u svežem stanju, od nje je supruga pravila izvrsne sokove, džemove i pekmeze, a ja kajsijevaču, rakiju koja bi mogla na svaku trpezu. Elem, kad sam je osmotrio sa svih strana i u mislima rasporedio koje grane treba uklanjati, a koje skraćivati, shvatim da nisam poneo merdevine. Pošto više ne mogu da se verem po drveću kao nekada, opet se vratim do šupe, gde su, sa spoljne strane zida, ispod nastrešnice, bile okačene merdevine. I tako, konačno donesem merdevine do kajsije, još jednom se presaberem šta i kako treba orezivati, popnem se na merdevine i – shvatim da nisam poneo makaze za orezivanje…
Biću fer pa ću vam priznati da mi je pamćenje od 2021-ve, posle preležanog kovida 19, otišlo u ofsajd. Tome treba dodati i učinak godina, pa vi vidite gde sam.
Dakle, vratim se opet do šupe, uzmem makaze pa krenem natrag do kajsije. Usput sam konstaovao da je na njima zavrtanj olabavljen, a ni oštrenje i podmazivanje im ne bi naškodilo, pa se vratim do radionice, koja je prislonjena uz šupu. Odvrnem zavrtanj, i da ga kasnije ne bih tražio, što mi se posle preležanog kovida često dešavalo, stavim ga na jedno mesto, kao: da znam gde je, da ne moram posle da ga tražim. Nađem grafitnu mast, podmažem dodirna pokretljiva mesta i – trebalo bi vratiti zavrtanj, ali njega nigde nema. Najgore je što ne mogu da se setim gde je to mesto gde sam ga ostavio, kao: za sigurno.
Istina, jedan naš poznati lekar, doktor nauka, tvrdio je da je kovid najsmešniji virus ikada. Valjda je po toj izjavi i postao poznat. Međutim, moje iskustvo je sasvim drugačije. Dok sam, sa obostranom upalom pluća, ležao u karantinu, boreći se sa tim smešnim virusom, doživeo sam i infarkt. Ali, uz svesrdnu negu medicinskog osoblja pretekao sam, mada su posledice bolesti ostale, jer ni lekari nisu svemogući. Osim zaboravnosti, ostala je i gluvoća na jedno uho, problemi sa ravnotežom, kao i zamaranje pri bilo kakvom naprezanju, tako da za mene i najobičnije orezivanje jedne voćke predstavlja ozbiljan zahvat.
Kao što i sami zaključujete, meni taj virus nije bio nimalo smešan!